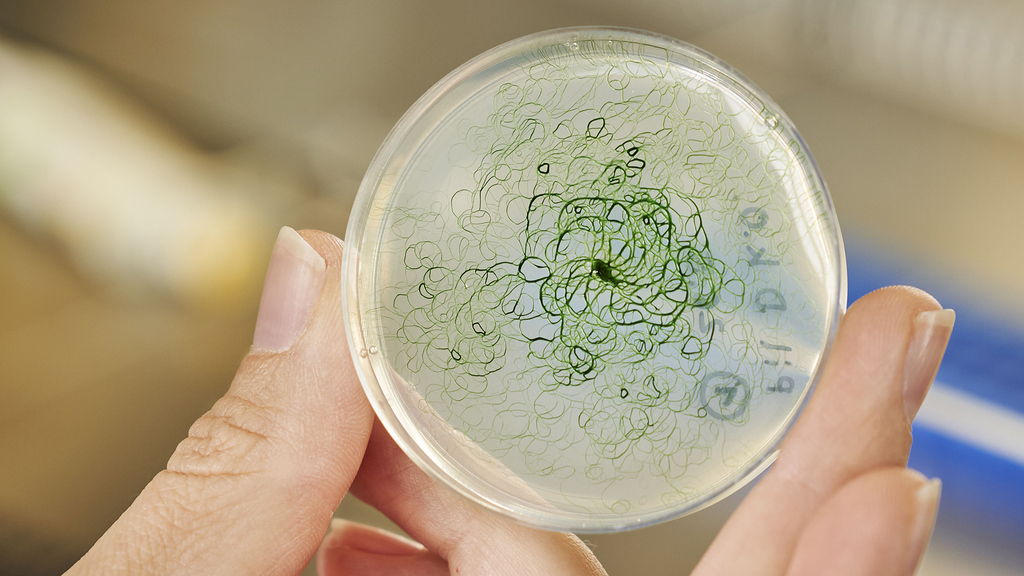
Cyanobakterien als Produzenten von Ethanol oder Wasserstoff – natürlicher Gentransfer könnte das möglich machen (Foto: Amadeus Bramsiepe, KIT)

![]() (21.12.2020)Oliver Kraft bleibt Vizepräsident für Forschung Optimale Rahmenbedingungen für exzellente Forschung und für den wissenschaftlichen Nachwuchs zentrale Themen Mehr |
![]() (21.12.2020)Thomas Hirth bleibt Vizepräsident für Innovation und Internationales Schwerpunkte sind Weiterentwicklung der Innovations- sowie Internationalisierungsstrategie, Stärkung des Wissenstransfers und Dialog mit der Gesellschaft Mehr |
![]() (17.12.2020)Real trifft digital: Modelle für hybride Lernumgebungen Forschende des KIT und der Universität Heidelberg wollen Schulen unterstützen. VolkswagenStiftung fördert Projekt mit 120 000 Euro Mehr |
![]() (17.12.2020)Katalysatorforschung: Molekulare Sonden erfordern hochgenaue Rechnungen Forschende des KIT setzen fortgeschrittene Methoden mit Hybridfunktionalen zur Analyse der aktiven Zentren ein – Publikation in Physical Review Letters Mehr |
![]() (16.12.2020)Weitere Schritte zur Vollendung der KIT-Fusion – Gesetz in Landtag eingebracht Präsident Holger Hanselka: „Gesetz zeigt Weg auf, wie wir am KIT die nächste Stufe der Einheit erklimmen können“ Mehr |
![]() (15.12.2020)Nachhaltigkeit im Blick: Lithium aus dem Oberrheingraben für Batterien Forschungsprojekt nutzt Tiefengeothermie für die Gewinnung des Rohstoffs – gefördert vom Bundesministerium für Wirtschaft und Energie Mehr |
![]() (15.12.2020)Dreidimensionaler Blick in aktive Katalysatoren Am KIT eingesetzte operando-Röntgenspektroskopie eröffnet neue Möglichkeiten für die Material- und Reaktionsdiagnostik Mehr |
![]() (14.12.2020)Frequenzdaten für stabile Stromversorgung Forschungsverbund untersucht Fluktuation in synchronen Netzgebieten – am KIT entwickelter Daten-Rekorder ermöglicht Datenaufzeichnung auf drei Kontinenten Mehr |
![]() (11.12.2020)Kaum Sport – aber mehr Bewegung im Lockdown Während der Schließung von Schulen und Sportvereinen hat die Alltagsaktivität von Kindern und Jugendlichen zugenommen Mehr |
![]() (11.12.2020)CO2-Emissionen: Rekord-Rückgang durch Corona Fossile CO2-Emissionen sind so stark zurückgegangen wie noch nie. Die atmosphärische CO2-Konzentration hingegen steigt weiter an. Mehr |
![]() (10.12.2020)Signifikanter Effekt von Schulschließungen Datenanalyse zur Wirkung von Corona-Maßnahmen: Studie zur Effektivität nichtpharmazeutischer Interventionen im Kampf gegen die Pandemie Mehr |
![]() (10.12.2020)Künstliche Intelligenz: So bleibt der Mensch im Mittelpunkt KIT koordiniert Verbundprojekt MeKIDI zur Digitalisierung von Prozessen in der Energiewirtschaft Mehr |
![]() (09.12.2020)ERC Consolidator Grants für zwei Forschende des KIT Exzellente Forschung zu Bindungen der Actinoide und zu energieeffizienter Kommunikationstechnik: Tonya Vitova und Laurent Schmalen erhalten je einen ERC Consolidator Grant Mehr |
![]() (09.12.2020)Kompostierbare Displays für nachhaltige Elektronik Forschende des KIT entwickeln gedrucktes Display, das biologisch abbaubar ist – Veröffentlichung im Journal of Materials Chemistry Mehr |
![]() (08.12.2020)KIT erhält Reallabor „Robotische Künstliche Intelligenz“ Künstliche Intelligenz durch humanoide Roboter erfahrbar machen: Bidirektionaler Austausch zwischen Gesellschaft und Forschung im Fokus Mehr |
![]() (08.12.2020)Klimawandel verschlimmert Biodiversitätsschwund Studie in PNAS: Revidierte Ziele für biologische Vielfalt nach 2020 müssen Erderwärmung berücksichtigen Mehr |
![]() (08.12.2020)Digital-Gipfel 2020: Methanausstoß aus der Nordsee verstehen Wissenschaftlerinnen und Wissenschaftler wollen lokale Methanquellen in der Nordsee mit hochauflösender Modellierung bewerten Mehr |
![]() (03.12.2020)Covid-19: Forecast Hub bündelt Prognosen Forschungsteam mit Beteiligung des KIT entwickelt Plattform für Kurzzeitvorhersagen zur Entwicklung der Corona-Pandemie in Deutschland und Polen Mehr |
![]() (03.12.2020)Neue Produktionstechnologie für schwere Nutzfahrzeuge Brennstoffzellen ressourcenschonend, flexibel und kostengünstig herstellen – Baden-württembergisches Wirtschaftsministerium fördert mit rund einer Million Euro Mehr |
![]() (02.12.2020)Dezentrale Energieversorgung durch innovative Strom-Wärme-Kopplung Praxistest für ein Redox-Flow-/Lithium-Ionen-Batteriepaar zur effizienten und ausdauernden Strom- und Wärmeversorgung Mehr |
![]() (02.12.2020)KIT top in Wirtschaftsingenieurwesen und Wirtschaftsinformatik Aktuelles Ranking des Centrums für Hochschulentwicklung (CHE) zählt die beiden Masterstudiengänge zu den Top Drei im deutschsprachigen Raum. Mehr |
![]() (01.12.2020)DFG fördert neuen Sonderforschungsbereich am KIT Ziel der Forschung des am KIT geförderten SFB "TrackAct" ist ein ganzheitliches Verständnis der katalytischen Prozesse zur Emissionskontrolle. Mehr |
![]() (30.11.2020)Fördererfolge für die Lehre am KIT Ministerium für Wissenschaft, Forschung und Kunst fördert Verbundprojekt „digiLAB – digitalisiertes Lernen in der Lehramtsausbildung“ des KIT. Mehr |
![]() (30.11.2020)Künstliche Intelligenz: Plattform Lernende Systeme nennt Prüfkriterien für Zertifizierung Wissenschaftler des KIT federführend an Whitepaper beteiligt. Vertrauen in KI-Systeme Voraussetzung für deren erfolgreiche Verbreitung. Mehr |
![]() (24.11.2020)Digitalisierung: Folgen für das Gesundheitswesen Forschungsteam des KIT untersucht Auswirkungen digitaler Technologien auf die Arbeit von medizinischem Fachpersonal. Projektförderung über drei Jahre. Mehr |
![]() (23.11.2020)KIT und Audi arbeiten an Recycling-Methode für automobile Kunststoffe Geschlossener Kreislauf für Kunststoffe aus dem Automobilbau: Abfälle aus technischen Kunststoffen werden zu Pyrolyseöl verarbeitet, das für neue Bauteile eingesetzt werden kann. Mehr |
![]() (20.11.2020)Rollendes Labor: KIT und AVG untersuchen Infrastruktur Messbahn nimmt die Schienen im Stadtbahntunnel genauer unter die Lupe. Projekt liefert Erkenntnisse über Abnutzung und betriebliche Optimierung. Mehr |
![]() (19.11.2020)Brandschutz: Notunterkünfte unzureichend geschützt Versuchsreihe des KIT identifiziert Schaumstoffmatratzen als möglichen Ausgangspunkt extremen Brandverhaltens Mehr |
![]() (19.11.2020)Auch Alltagsaktivitäten steigern das Wohlbefinden Neurobiologische Mechanismen untersucht: Neue Erkenntnisse zum Zusammenhang von körperlicher Aktivität und Wohlbefinden im Alltag. Mehr |
![]() (18.11.2020)RABus bringt selbstfahrende Busse auf die Straße Neues Verbundprojekt testet elektrifizierte und automatisierte Fahrzeuge im regulären Verkehr – KIT erforscht Akzeptanz und Wirkungen. Mehr |
![]() (18.11.2020)„Highly Cited Researchers“ aus dem KIT Acht Forschende des KIT sind dieses Jahr unter den meistzitierten Wissenschaftlerinnen und Wissenschaftlern weltweit Mehr |
![]() (16.11.2020)Digitale Prüfungen: Forschende untersuchen Potenziale Projekt des KIT unter den besten 100 Ideen. Förderung durch Jubiläumsinitiative des Stifterverbandes. Mehr |
![]() (13.11.2020)KIT wird Zentrum für Nationales Hochleistungsrechnen Millionenförderung für künftige Supercomputer am KIT – Forschende in ganz Deutschland können enorme Karlsruher Rechenleistung nutzen. Mehr |
![]() (13.11.2020)3D-Bilddaten: Bessere Auswertung durch Automatisierung Team von KIT und Partnern stellt Open-Source-Plattform für die Segmentierung von Volumenbildern vor. Veröffentlichung in Nature Communications. Mehr |
![]() (12.11.2020)Aerobuster jagt herumfliegende Corona-Viren Forschende des KIT bauen preiswerten und leistungsstarken Apparat, der Krankheitserreger aus der Raumluft holen und inaktivieren kann. Mehr |
![]() (10.11.2020)Green Deal: Gut für Europa – schlechter für den Planeten Import von Millionen Tonnen Getreide und Fleisch untergräbt landwirtschaftliche Standards der EU – Umweltschäden werden so ausgelagert. Mehr |
![]() (05.11.2020)Besser beschleunigen mit Künstlicher Intelligenz Neues Projekt vom Deutschen Elektronen-Synchrotron und vom Karlsruher Institut für Technologie erforscht autonome Teilchenbeschleuniger. Mehr |
![]() (05.11.2020)Enorme Beschleunigung für die Medikamentenforschung Prozesse können 10 000-mal schneller ablaufen – Europäischer Forschungsrat fördert Forscher des KIT und Partner im Projekt HiSCORE. Mehr |
![]() (05.11.2020)Vortragsreihe: Kulturwissenschaft gestern und morgen „Das vom Menschen Gemachte“: Colloquium Fundamentale am KIT widmet sich im Wintersemester der Disziplin zur Erforschung der Kultur. Mehr |
![]() (02.11.2020)Biologie trifft Chemie – Forschungsneubau bezogen Interdisziplinäre Forschung auf 5 800 Quadratmetern am Campus Nord des KIT. Am 29. Oktober 2020 wurde der Neubau feierlich eingeweiht. Mehr |
![]() (27.10.2020)Stromtransport: Längstes Hochspannungs-Supraleiterkabel der Welt In München soll das längste Supraleiterkabel der Welt realisiert und wirtschaftlich eingesetzt werden. Das KIT ist an dem Projekt beteiligt. Mehr |
| (27.10.2020)Facebook Research Award für SECUSO Die Forschungsgruppe SECUSO des Karlsruher Instituts für Technologie gewinnt gemeinsam mit der University of Denver einen Research Award von Facebook. Mehr |
![]() (26.10.2020)Arzneimittelentwicklung: Prozessschritte auf einem Chip vereint Neue Funktionalisierung von Glasoberflächen ermöglicht ressourcenschonende Herstellung, Analyse und biologische Untersuchung neuer Wirkstoffe. Mehr |
![]() (23.10.2020)Blutgefäße gezielt und schnell vergrößern Forschende des KIT stimulieren gezielte Vergrößerung von Endothelzellen in Arteriolen – Grundlagen für eine bessere Behandlung von Herzinfarkten und Schlaganfällen Mehr |
![]() (21.10.2020)Klimawandel: Schutz für Kulturreben und Stadtbäume Forschungsteam untersucht, wie sich Wildreben gegen Pilze wehren, und überträgt diese Erkenntnisse auf den Schutz von Bäumen im städtischen Raum. Mehr |
![]() (21.10.2020)Klimaforschung: Neue Videoserie zur Auswirkung der Corona-Pandemie Forscher vom KIT spricht über die Auswirkungen der Krise auf die Luftverschmutzung über China. Deutlicher Rückgang im Frühjahr 2020 beobachtet. Mehr |
![]() (20.10.2020)KI übertrifft Mensch bei Spracherkennung Forscherinnen und Forscher am KIT haben weltweit erstes Spracherkennungssystem entwickelt, das besser arbeitet als der Mensch und schneller ist als andere KIs Mehr |
![]() (19.10.2020)Forschungsorientierte Lehre: Von der Idee zum Produkt Neues Lern- und Anwendungszentrum Mechatronik für bis zu 1 000 Studierende pro Semester entsteht. Firma Trumpf fördert Projekt. Mehr |
| (16.10.2020)Metalle: Neuer Mechanismus bei Verformungen Deutsch-französisches Team entdeckt bisher unberücksichtigten Mechanismus der Verfestigung bei Metallen. Mehr |
| (16.10.2020)Neue Erkenntnisse zur embryonalen Entwicklung von Wirbeltieren Forschende des KIT haben erstmals die Rolle des Proteins MondoA während der Embryonalentwicklung untersucht und eine enge Verschaltung von Stoffwechsel und Entwicklungsvorgängen belegt. Mehr |
![]() (16.10.2020)Künstliche Intelligenz zum Schutz des Grundwassers Bundesumweltministerium bewilligt KI-Leuchtturmprojekt „Nitrat-Monitoring 4.0“ für die Reduzierung von Nitrat im Grundwasser Mehr |
![]() (15.10.2020)Langfristig Zugriff auf Forschungsdaten sichern Eröffnung der Geschäftsstelle der Nationalen Forschungsdateninfrastruktur (NFDI) in Karlsruhe Mehr |
![]() (15.10.2020)Jung bleiben im Alter mit Assistenzrobotern KIT entwickelt neue Generation von personalisierbaren humanoiden Robotern für Senioren – Carl-Zeiss-Stiftung fördert Projekt mit 4,5 Millionen Euro Mehr |
![]() (14.10.2020)Mobilität in der Stadt: Miteinander oder in der Quere In dem neuen Verbundprojekt „Cape Reviso“ ermitteln Forschende des KIT, wie Radfahrer und Fußgänger sich fühlen, wenn sie im Verkehr aufeinandertreffen Mehr |
![]() (12.10.2020)Weltweite Klima-Zusammenhänge anschaulich machen Welche Trends im Klimawandel zeichnen sich ab und welche Einflüsse haben sie auf unser tägliches Leben? Ein interaktiver Präsentationsglobus am KIT ermöglicht ungewöhnliche Ansichten unserer Erde. Mehr |
![]() (08.10.2020)Ethikleitfaden für Künstliche Intelligenz Plattform Lernende Systeme veröffentlicht neues Whitepaper zur Entwicklung sicherer, nachvollziehbarer und diskriminierungsfreier KI-Anwendungen Mehr |
![]() (08.10.2020)Globale Nahrungsmittelproduktion bedroht das Klima Einsatz von Stickstoffdüngern in der Landwirtschaft lässt Lachgaskonzentration in der Atmosphäre stark steigen – Studie unter Beteiligung des KIT in Nature Mehr |
![]() (08.10.2020)Artenverlust betrifft Lebensgrundlagen des Menschen Jena Experiment: Biodiversität entscheidet über Funktionieren von Ökosystemen – Ergebnisse in Nature Ecology & Evolution Mehr |
![]() (07.10.2020)Katastrophenmanagement: Neuer Bericht des CEDIM Interdisziplinäre Einrichtung des KIT stellt Aktivitäten von 2017 bis 2020 vor. Ausbreitung von Covid-19 aktuelles Thema. Mehr |
![]() (06.10.2020)Saisonale Prognosen verbessern die Lebensmittelversorgung EU-Projekt CONFER gestartet – Niederschlagsvorhersagen verringern die Auswirkungen von Dürren und Überschwemmungen in Ostafrika Mehr |
![]() (05.10.2020)Sportwissenschaft: Qualität gewinnt Spiele Erfolgsfaktoren im Fußball vor allem eine gute Defensive, präzise und effiziente Spielaktionen sowie teure Spieler Mehr |
![]() (01.10.2020)Staus und Schadstoffemissionen im Straßenverkehr reduzieren Projekt des Bundesverkehrsministeriums zur Optimierung von Streckenbeeinflussungsanlagen auf Autobahnen gestartet Mehr |
![]() (30.09.2020)Energie System 2050: Lösungen für die Energiewende Die Forschungsinitiative der Helmholtz-Gemeinschaft präsentiert Strategien, Technologien und Open-Source-Werkzeuge Mehr |
![]() (30.09.2020)Auswirkungen des Wetters auf Grippewellen Internationales Forschungsteam untersucht Zusammenhang zwischen spezifischen Wetterlagen und Influenza. Verbesserte Prognose von Infektionswellen möglich. Mehr |
![]() (28.09.2020)Neuer Forschungspodcast „Selbstbewusste KI“ Expertinnen und Experten diskutieren Fragen rund um das Bewusstsein von Künstlicher Intelligenz Mehr |
![]() (24.09.2020)Streckbank für Zellen Eine raffinierte, wenige Mikrometer kleine Vorrichtung macht es möglich, die Reaktion einzelner biologischer Zellen auf mechanischen Stress zu untersuchen Mehr |
![]() (23.09.2020)Entwicklung ultra-kompakter Radarsensoren für Unternehmen DFG und FhG fördern Projekt zum Transfer von wissenschaftlichen Erkenntnissen des KIT in die Wirtschaft Mehr |
![]() (23.09.2020)Klimawandel: Einfluss von Lachgas näher untersucht Tierhaltung in Afrika stellt eine bisher stark unterschätzte Quelle des Treibhausgases N2O dar Mehr |
![]() (22.09.2020)Edelmetallcluster können Katalysatoren leistungsfähig machen und Ressourcen schonen Optimierte Verteilung von Atomen erlaubt kostengünstigere Produktion - Publikation in Nature Catalysis Mehr |
![]() (21.09.2020)Open Source für das Energiesystem der Zukunft Die Initiative „Energie System 2050“ hat den Umbau des Energiesystems untersucht. Holger Hanselka, Präsident des KIT und Koordinator der Initiative, zieht Bilanz. Mehr |
![]() (21.09.2020)Innovative Technik für nachhaltiges autonomes Fahren Modulares Konzept „U-Shift“ ermöglicht immer neue Fahrzeugvarianten Mehr |
| (18.09.2020)Ausgezeichnet: Digitalisierung für die Erdsystemforschung Das Projekt "Digital Earth" unter Beteiligung des KIT wurde beim Digital Leader Award mit einem Sonderpreis für Digital Science ausgezeichnet. Mehr |
| (17.09.2020)EIN Förderverein für EIN KIT KIT-Fördergesellschaft und Freundeskreis des Forschungszentrums Karlsruhe schließen sich zusammen Mehr |
![]() (16.09.2020)Einsatz für die Wasserqualität in Südvietnam Forschende des KIT tragen zur Verbesserung der Wasserversorgung im Mekongdelta bei. Mehr |
![]() (15.09.2020)Geringere CO2-Emissionen durch Corona-Beschränkungen noch nicht in der Atmosphäre erkennbar Auswirkungen der Pandemie zeigen sich in der Atmosphäre erst spät – Zum Erreichen der Pariser Klimaziele sind jahrzehntelange Maßnahmen erforderlich Mehr |
![]() (09.09.2020)Neuartiger Fotolack ermöglicht 3D-Druck kleinster poröser Strukturen Forschende des Exzellenzclusters 3D Matter Made to Order erweitern die Möglichkeiten des Zwei-Photonen-Mikrodrucks Mehr |
![]() (08.09.2020)Terahertz-Empfänger für 6G-Mobilfunknetze Am KIT entwickeltes Konzept ermöglicht hohe Datenübertragungsraten bei niedrigen Kosten – bislang höchste Datenrate in der Terahertz-Kommunikation Mehr |
![]() (04.09.2020)Vererbung bei Pflanzen lässt sich nun gezielt steuern Forschende am KIT verändern mit der molekularen Schere CRISPR/Cas erstmals Abfolge der Gene innerhalb eines Chromosoms – Nature Communications veröffentlicht Ergebnisse Mehr |
![]() (03.09.2020)DNA-Schäden durch wandernde Lichtenergie UV-Strahlung verändert DNA auch sehr weit entfernt von der Eintrittsstelle des Lichts – Veröffentlichung in der Fachzeitschrift Angewandte Chemie Mehr |
![]() (02.09.2020)Elektroden schneller trocknen – Batterien kostengünstiger herstellen Das am KIT koordinierte Projekt EPIC zielt auf energetische, ökonomische und ökologische Optimierung der Produktion Mehr |
![]() (31.08.2020)Neues Verfahren: Steroidhormone effizient aus Wasser entfernen Verbessertes Filtrationssystem aus Polymermembran mit aktiviertem Kohlenstoff eliminiert Östradiol zu mehr als 99 Prozent Mehr |
![]() (28.08.2020)Neues Wohnheim für Studierende Studentenwohnheim des Karlsruher Instituts für Technologie e.V. und Schroff Stiftungen schaffen Wohnraum für 103 Studierende Mehr |
![]() (24.08.2020)Photovoltaik: Mehr Energie mit Tandemzellen Forschungsprojekt will mit Perowskit-Silizium-Solarzellen Wirkungsgrade von bis zu 33 Prozent erreichen Mehr |
![]() (24.08.2020)Corona-Pandemie: Erreger im Abwasser Internationales Forschungsteam berichtet über mögliches Gesundheitsrisiko. Veröffentlichung in Nature Sustainability Mehr |
![]() (19.08.2020)Elektromobilität: Potenziale aufdecken Im Projekt Fit4E identifiziert das KIT Fertigungskompetenzen von KMU. Wichtigste Erkenntnisse in Leitfaden veröffentlicht. Mehr |
![]() (19.08.2020)Schroff Kolleg: Neues Wohnheim für Studierende des KIT Mit Unterstützung der Schroff Stiftungen entsteht in der Hagsfelder Allee zusätzlicher Wohnraum mit Platz für 103 Studierende Mehr |
![]() (17.08.2020)Flexibles Produktionssystem für Variantenvielfalt Ingenieure des KIT und Industriepartner arbeiten an der wirtschaftlichen Fertigung von individualisierten Industrie- und Konsumgütern Mehr |
![]() (13.08.2020)Klimawandel: Mischwälder sind anpassungsfähiger als Monokulturen Wissenschaftlerinnen und Wissenschaftler des KIT und der Universität Freiburg untersuchen den Umbau von Rein- in Mischbestände – Buchen-Tannen-Mischungen mit hohem Potenzial Mehr |
![]() (12.08.2020)Rohstoffe für Energie- und Mobilitätstechnologien Geologen untersuchen im Oberrheingraben Prozesse der Metallanreicherung in Geothermalwässern – DFG-Projekt erforscht potenzielle Wertstoffe in Tiefenwässern |
![]() (11.08.2020)Effiziente Gastrennung dank poröser Flüssigkeiten Neues Material eröffnet die Möglichkeit, beim Abtrennen von Rohstoffen für die Kunststoffindustrie bis zu 80 Prozent Energie einzusparen – Publikation in Nature Materials Mehr |
![]() (10.08.2020)Energie für ein klimaneutrales Europa Landesumweltminister Untersteller zu Besuch am KIT Mehr |
| (10.08.2020)Datenschutzfreundliche Überwachung in Zeiten der Corona-Pandemie Forschende am KIT entwickeln System zu bildbasierten Erkennung von Masken Mehr |
| (07.08.2020)Shanghai-Ranking: KIT belegt weltweit Spitzenplätze Metallurgie, Atmosphärenforschung und Energiewissenschaften in Deutschland auf Platz 1 Mehr |
![]() (29.07.2020)Technologiekalender unterstützt Unternehmen beim Wandel Studie vergleicht Mobilitätsszenarien und hilft bei strategischen Entscheidungen Mehr |
![]() (28.07.2020)Anodenmaterial für sichere und langlebige Batterien Lithium-Lanthan-Titanat-Partikel ermöglichen selbst in Mikrometergröße hohe Leistungsdichten Mehr |
![]() (22.07.2020)Regenmessung mit dem Mobilfunknetz Niederschlagsbedingte Abschwächung der Funkverbindung ermöglicht zeitlich hoch aufgelöste Regenkarten Mehr |
![]() (21.07.2020)Open Source für die globale Energiewende Energy Computing Initiative der Helmholtz-Gemeinschaft unterstützt die klimafreundliche Transformation von Energiesystemen Mehr |
![]() (17.07.2020)EU-Projekt soll Batterieentwicklung beschleunigen In der europäischen Initiative BATTERY 2030+ startet eine neuartige Batterieentwicklungsstrategie Mehr |
| (14.07.2020)Aerosole beeinflussen Solarstromertrag in Europa Forschungsprojekt untersucht, wie winzige Schwebeteilchen in der Luft das Wetter und die Sonneneinstrahlung verändern Mehr |
| (14.07.2020)Landesrektorenkonferenz zum Wintersemester 2020/21 Digitalbetrieb in Baden-Württemberg wird fortgesetzt. Ziel ist so viel Präsenzlehre wie möglich. Mehr |
![]() (13.07.2020)Verbesserte Prüfverfahren für Batteriesysteme Das KIT arbeitet gemeinsam mit Partnern an neuen Prüfverfahren und Normen für Lithium-Ionen-Zellen in Batteriesystemen Mehr |
| (13.07.2020)Neue Architekturen für die Mobilität der Zukunft UNICARagil präsentiert zentrale Forschungsergebnisse und erste Prototypen fahrerloser Fahrzeugkonzepte. Mehr |
| (13.07.2020)Wissenschaftsplattform Klimaschutz zum Corona-Konjunkturpaket Stellungnahme zu Anforderungen an die Ausgestaltung von Konjunkturpaketen. Mehr |
| (10.07.2020)Hilfe gegen Fake Shops KIT an Forschungsprojekt INSPECTION beteiligt, das Manipulationen an Webseiten erkennen und Betroffene informieren soll. Mehr |
![]() (09.07.2020)KIT forscht in vier neuen Batterie-Kompetenzclustern Verbünde zu Agiler Produktion, Recycling, Nutzungskonzepte und Qualitätssicherung Mehr |
![]() (08.07.2020)Automatisiertes Belastungsmanagement Forscherinnen und Forscher des KIT entwickeln anpassungsfähige Mensch-Maschine-Schnittstelle für Mähdrescher Mehr |
| (06.07.2020)Regionaldialog „Nachhaltige urbane Mobilität" Das KIT lädt zu einem Gespräch über die zukünftige Stadtgestaltung ein. Die Veranstaltung findet sowohl online, als auch im Reallabor 131 statt. Mehr |
![]() (06.07.2020)Superschnelles KI-System am KIT installiert Eines der leistungsstärksten KI-Computersysteme in Europa unterstützt ab sofort bei der Lösung von Menschheitsproblemen Mehr |
| (30.06.2020)Schroff-Hochbegabten-Stipendien 2020 verliehen Elf Studierende des KIT erhielten ein Hochbegabten-Stipendium der Gunther-Schroff-Stiftung für wissenschaftliche Zwecke. Mehr |
| (26.06.2020)Trockenheit im Frühjahr verstärkt Dürre im Sommer International Kooperation untersucht Ursachen für Dürre. Durch Landmanagement Hitzewellen begegnen. Mehr |
![]() (25.06.2020)Rohstoffsynthese durch Gentransfer Cyanobakterium lässt sich für Grundlagenforschung und biotechnische Anwendungen nutzen Mehr |
![]() (25.06.2020)Plattentektonik: Wie Wasser Erdbeben und Vulkanismus verursacht Internationales Forschungsteam hat Zusammenhänge auf den Kleinen Antillen untersucht. Veröffentlichung in Nature. Mehr |
| (24.06.2020)Führung und soziale Interaktion in digitalen Teams Im Projekt "teamIn" wird ein wissenschaftlich fundiertes und industriell erprobtes Leitbild für das digitale Arbeiten entwickelt. Mehr |
![]() (22.06.2020)COVID-READY hilft Hotels in und nach der Pandemie Ausgründung aus dem KIT unterstützt mit ihrem kostenfreien Angebot und bietet Software und Zertifizierung für Hygiene- und Schutzmaßnahmen. Mehr |
![]() (19.06.2020)Coronavirus: Wintersemester startet später KIT plant angepasste Vorlesungszeiten und Prüfungsphasen. Wintersemester 2020/21 startet am 02.11.2020. Mehr |
| (16.06.2020)Stark in Forschung und Wissenstransfer KIT bei internationalen Vergleichen U-Multirank und QS-Ranking erfolgreich Mehr |
![]() (15.06.2020)Nationale Wasserstoffstrategie Präsident Holger Hanselka im Interview über die Rolle von Wasserstoff in der zukünftigen Energieversorgung. Mehr |
![]() (12.06.2020)Maximal 20 pro Jahr: Ein klares Ziel für den Artenschutz Wissenschaftlerinnen und Wissenschaftler fordern mit Grenzwert für die Zahl ausgestorbener Spezies ähnlichen Grundsatz wie für den Klimaschutz Mehr |
| (12.06.2020)Hightech-Forum: Innovationspolitik nach der Corona-Krise Gremium skizziert sieben Leitlinien für neues Wachstum Mehr |
![]() (09.06.2020)Phishing-Kampagnen und ihre Fallstricke Forscherinnen analysieren die Wirkung vorgetäuschter Phishing-Mails zur Sensibilisierung von Angestellten Mehr |
![]() (08.06.2020)KI unterstützt bei der Montage Digitaler Montageassistent ermöglicht kontaktlose Zusammenarbeit von Menschen und Maschinen Mehr |
![]() (05.06.2020)Neue Quantenmaterialien Wechselwirkungen zwischen mechanischen und elektronischen Eigenschaften bergen großes Anwendungspotenzial Mehr |
![]() (04.06.2020)Besser gerüstet gegen Waldbrände Forschungsprojekt trägt dazu bei, die Dynamik von Waldbränden zu verstehen und das Risiko zu senken Mehr |
![]() (03.06.2020)Kavli-Preis für Wegbereiter der Elektronenmikroskopie Maximilian Haider, Harald Rose, Knut Urban und Ondrej Krivanek werden mit dem Kavli-Preis 2020 ausgezeichnet Mehr |
![]() (02.06.2020)Coronavirus: Reproduktionszahl genauer geschätzt Forscher des KIT entwickeln neue Methode mit akausalem Sieben-Tage-Filter zur Bestimmung des R-Werts Mehr |
(29.05.2020)Datenschutz beim Website-Tracking Informatiker des KIT und der TU Dresden untersuchen, wie gut das Generalisieren von Trackingdaten Spuren im Internet verwischt Mehr |
| (29.05.2020)KIT an neuem SFB/Transregio beteiligt Die Deutsche Forschungsgemeinschaft richtet zehn neue Sonderforschungsbereiche ein. An einem ist das KIT beteiligt. Mehr |
![]() (28.05.2020)Am KIT finden wieder schriftliche Klausuren statt Kooperation mit der Messe Karlsruhe ermöglicht es großen Gruppen von Studierenden verschobene Präsenzprüfungen nachzuholen Mehr |
| (27.05.2020)Sicherheit im E-Mail-Verkehr Die Forschungsgruppe SECUSO hat ihr Add-on TORPEDO aktualisiert. Es hilft, betrügerische Nachrichten mit Bezug zu SARS-CoV-2 zu erkennen. Mehr |
![]() (27.05.2020)Schadstoffkonzentration während der Corona-Pandemie Das Projekt BLUESKY untersucht die Effekte, die das Herunterfahren des gesellschaftlichen und wirtschaftlichen Lebens auf die Atmosphäre hat. Mehr |
![]() (26.05.2020)Mit KI in der Landwirtschaft Wasser sparen Das Start-up heliopas.ai aus dem KIT hilft Landwirten mit der Smartphone-App „Waterfox“ ihre Felder effizienter zu bewässern Mehr |
![]() (25.05.2020)Neue Technik zur Genomveränderung CRISPR/Cas revolutioniert Pflanzenzüchtung über gezieltes Kombinieren von Eigenschaften Mehr |
![]() (20.05.2020)Neue Lösungen für textile Biogasspeichersysteme Forscherinnen und Forscher des KIT haben mit einer Testanlage untersucht, wie sich textile Speicher für Biogas verbessern lassen Mehr |
| (19.05.2020)Wie effizient arbeiten Photovoltaik-Speichersysteme? Projekt „Testbench“ verbessert Qualität der Messergebnisse und erleichtert den Vergleich. Mehr |
![]() (15.05.2020)Ethiklabel für KI-Technologien Das Ethiklabel ist optisch an das Energieeffizienzlabel für elektronische Geräte angelehnt. Mehr |
![]() (14.05.2020)Neuer Supercomputer für das KIT Hybridsystem „HoreKa“ voraussichtlich einer der zehn schnellsten Rechner in Europa in 2021 Mehr |
![]() (14.05.2020)Neuer Forschungsschwerpunkt am KIT Nachhaltige Produktion: Kreislaufwirtschaftssystem in Produktionsprozessen ermöglichen Mehr |
![]() (13.05.2020)Bakterien als Stromlieferanten Programmierbares, biohybrides Materialsystem nutzt Bakterien zur Erzeugung von Strom. Mehr |
| (12.05.2020)Neue Moleküle für Hightech-Materialien Deutsche Forschungsgemeinschaft fördert Arbeit an Sandwich-Komplexen von Peter Roesky über ein Reinhart Koselleck-Projekt Mehr |
![]() (12.05.2020)Grunwald im Vorsitz des NBG Die Mitglieder des Nationalen Begleitgremiums (NBG) haben Armin Grunwald zum neuen Co-Vorsitzenden gewählt. Mehr |
![]() (07.05.2020)Datenschutzfreundliche Corona-Tracing-App KIT und FZI entwickeln Kompromissvorschlag aus zentraler und dezentraler Lösung für eine höhere Privatsphäre Mehr |
| (04.05.2020)Agiles Produktionssystem für Elektromotoren Baden-württembergisches Wirtschaftsministerium fördert Forschungsprojekt am KIT mit rund einer Million Euro Mehr |
![]() (29.04.2020)Livestream: Vortragsreihe Bioökonomie Colloquium Fundamentale widmet sich den Herausforderungen einer nachhaltigen, biobasierten Wirtschaftsweise Mehr |
| (28.04.2020)Datenschutz bei Corona-Tracing-Apps Professor Thorsten Strufe und sein Team haben zentrale und dezentrale Ansätze einander gegenübergestellt und untersucht Mehr |
| (27.04.2020)KIT weiterhin bei Personalchefs beliebt Absolventen des KIT stehen bei Personalverantwortlichen deutscher Unternehmen weiter hoch im Kurs. Mehr |
![]() (23.04.2020)KARA unterstützt Corona-Forschung Mit dem Karlsruher Forschungsbeschleuniger (KARA) stellt das KIT eine weitere Infrastruktur zur Verfügung. Mehr |
| (21.04.2020)5G-Testumgebung in Karlsruhe Vernetzte Industrie im Fokus - Forschungsprojekt adressiert kleine und mittelständische Unternehmen. Mehr |
![]() (20.04.2020)Corona-Pandemie: Forschung und Hilfsaktivitäten am KIT Das KIT unterstützt bei der Bewältigung der Corona-Krise mit Forschungs- und Sachbeiträgen und wissenschaftlich-technischen Dienstleistungen. Mehr |
![]() (15.04.2020)Duftstoff der Minze hemmt Wachstum von Unkräutern Neuer Ansatz für nachhaltige Unkrautbekämpfung untersucht biologische Kommunikation zwischen Pflanzen Mehr |
![]() (14.04.2020)KIT unterstützt Karlsruher Kliniken mit Schutzausrüstung Corona-Hilfe: Masken und Visiere gehen unter anderem an Städtisches Klinikum und ViDia Kliniken Mehr |
![]() (14.04.2020)Auf der Suche nach dem Z‘-Boson Wissenschaftler des KIT sind an Beschleuniger-Experiment Belle II beteiligt, das nun erste Ergebnisse veröffentlicht hat Mehr |
| (14.04.2020)Land fördert „Virtuelle Kollaborationslabore“ am KIT Wissenschaftsministerium fördert Forschung zu Virtual- und Augmented-Reality- Lern- und Lehrkonzepten an Hochschulen. Mehr |
![]() (09.04.2020)Roadmap für die Batterieforschung in Europa Die europäische Forschungsinitiative BATTERY 2030+ präsentiert ihre Ziele – Forschungsplattform CELEST beteiligt Mehr |
![]() (08.04.2020)Ortung von in Not geratenen Rettungskräften Forschende des KIT entwickeln Technologie, um verletzte oder verschüttete Einsatzkräfte – ohne GPS – zu lokalisieren Mehr |
![]() (07.04.2020)Sommersemester startet online Der Studienbetrieb am Karlsruher Institut für Technologie läuft mit rein digitalen Angeboten am 20. April 2020 an. Mehr |
| (01.04.2020)Vereinbarung zur Hochschulfinanzierung unterzeichnet Präsident Holger Hanselka: „Können für die nächsten Jahre verlässlich planen“ Mehr |
| (01.04.2020)Hightech-Forum: Wege zum agilen Staat Das Gremium fordert einen übergreifenden Kulturwandel in der öffentlichen Verwaltung Mehr |
![]() (31.03.2020)Skalierbare Algorithmen für viele Anwendungen Der Europäische Forschungsrat fördert das Projekt „ScAlBox“ von Peter Sanders mit einem Advanced Grant. Mehr |
| (30.03.2020)Arbeiten in der Zeit der Pandemie Eine kompakte Handreichung hilft Unternehmen, die ihre Mitarbeiterinnen und Mitarbeiter ins Homeoffice schicken müssen. Mehr |
![]() (30.03.2020)Neue Materialien Nanostrukturierte Polymerfolie erreicht weiße Optik ohne Einsatz von umweltbelastendem Titandioxid – Käferpanzer als Vorbild. Mehr |
| (27.03.2020)Corona-Pandemie: Folgen der Krise Armin Grunwald, Experte für Technikfolgenabschätzung, über die gesellschaftlichen und technischen Folgen der Krise. Mehr |
| (25.03.2020)Geothermie - Baustein für die Energiewende Landesregierung Baden-Württemberg will den Ausbau der Tiefen Geothermie im Land voranbringen. Mehr |
![]() (25.03.2020)Vom Treibhausgas zum Hightech-Rohstoff Am KIT entsteht eine Versuchsanlage zur Umwandlung von CO2 aus der Umgebungsluft in festen Kohlenstoff. Mehr |
![]() (24.03.2020)Datenanalyse: Ausbreitung des Coronavirus KIT und Risklayer sammeln aktuelle Daten über die Entwicklung der Corona-Pandemie. Mehr |
| (23.03.2020)Baubeginn für das InformatiKOM Klaus Tschira Stiftung errichtet zwei Institutsgebäude für das Karlsruher Institut für Technologie Mehr |
![]() (17.03.2020)Pflanzenschutz ohne Giftkeule Vom KIT koordiniertes transnationales Netzwerk erforscht chemische Signale zwischen Krankheitserreger und Pflanze. Mehr |
![]() (12.03.2020)Coronavirus / COVID-19: Veranstaltungsabsagen am KIT Laut Verordnung des Landes Baden-Württemberg finden zunächst bis zum 15. Juni 2020 keine öffentlichen Zusammenkünfte, Konferenzen und sonstigen Versammlungen und Veranstaltungen statt. Mehr |
![]() (05.03.2020)Treibhausgasbedingter Klimawandel Bei extremer Hitze und Trockenheit profitieren Bäume kaum von erhöhtem CO2. Mehr |
| (05.03.2020)Sicherheit und Privatheit im E-Mail-Verkehr Informatikerin des KIT erhält den „Google Faculty Research Award“ für ihre Forschung zu link-zentrierten Phishing-Warnungen für Online-E-Mail-Kunden. Mehr |
![]() (04.03.2020)Fragen und Antworten im Umgang mit dem Coronavirus Aktualisierte FAQ: Durchführung der Klausuren im Sommersemester 2020 / Präsenzbesprechungen und sonstige Zusammenkünfte (Stand: 14.07.2020) Mehr |
| (04.03.2020)KIT in neun Fächern unter den Top 100 der Welt QS World University Rankings by Subject 2020 – KIT stark in Natur und Ingenieurwissenschaften Mehr |
![]() (02.03.2020)York Sure-Vetter vom KIT wird Direktor der NFDI FIZ Karlsruhe und KIT mit Aufbau des Direktorats der Nationalen Forschungsdateninfrastruktur (NFDI) betraut. Mehr |
![]() (24.02.2020)Datenbasiert zu optimierten Energiesystemen Start-up greenventory bietet Daten und Software für Versorger und Netzbetreiber, Städte und Quartiere Mehr |
![]() (17.02.2020)Hasso Plattner erhält Ehrendoktorwürde Der Unternehmer, Stifter und Mäzen besuchte das KIT zur feierlichen Übergabe der Urkunde Mehr |
![]() (17.02.2020)Batteriezellen flexibel produzieren Im Forschungsprojekt AgiloBat arbeiten KIT und Partner an der Zukunft der Batteriefertigung in Deutschland Mehr |
![]() (11.02.2020)Innovative Power-to-Gas-Technologien Unterschiedliche Verfahren zur Produktion von synthetischem Erdgas aus erneuerbarem Strom im Projekt STORE&GO entwickelt Mehr |
![]() (04.02.2020)Wissenschaftspreis der Hector Stiftung geht an Physiker des KIT Wolfgang Wernsdorfer erhält 150 000 Euro Preisgeld für seine Beiträge zum Quantencomputing Mehr |
![]() (03.02.2020)Mit KI Werkzeugmaschinen warten Verschleiß in Kugelgewindetrieben kann mit einem intelligenten System überwacht und bewertet werden Mehr |
![]() (03.02.2020)Dorothea Wagner ist neue Vorsitzende des Wissenschaftsrats Informatikerin des KIT an die Spitze von Deutschlands wichtigstem forschungspolitischem Beratungsgremium gewählt Mehr |
![]() (30.01.2020)Exzessives Sporttreiben bei Essstörungen Psychologische Mechanismen entschlüsselt: Ergebnisse liefern wichtige Implikationen für Prävention und Therapie Mehr |
| (29.01.2020)Coronavirus: Aktuelle Informationen Die Medizinischen Dienste des KIT haben die Informationsseite rund um den Coronavirus aufgrund der gegenwärtigen Lage aktualisiert. Mehr |
![]() (28.01.2020)Schnellster hochpräziser 3D-Drucker Neues 3D-System druckt submikrometergenaue Strukturen in Rekordgeschwindigkeit Mehr |
![]() (27.01.2020)Girls' Day 2020: Studium und Ausbildung am KIT Informationstag für Schülerinnen ab der fünften Klasse mit Workshops, Führungen und Vorträgen – Anmeldung jetzt möglich! Mehr |
![]() (23.01.2020)Wissenschaftsjahr 2020 - Bioökonomie Forschende des KIT arbeiten an neuen Technologien, die nachwachsende Ressourcen als Alternative zu fossilen Rohstoffen etablieren Mehr |
![]() (22.01.2020)ENERGIE – Wende. Wandel. Wissen. Neue Veranstaltungsreihe des KIT informiert über Energiewende und Energieforschung Mehr |
![]() (21.01.2020)KIT im Rathaus: Städte und Wetterextreme Bei der Veranstaltung stellt sich das KIT-Zentrum Klima und Umwelt mit seiner Forschung vor Mehr |
![]() (16.01.2020)Ein bisschen gut ist gut genug – Ausreden beim Konsum Studie des KIT zeigt, dass einzelne ethische Verbesserung ausreicht, um unmoralisches Verhalten zu rechtfertigen. Mehr |
![]() (13.01.2020)Mit Produktionstechnik zur nachhaltigen Mobilität Im Innovationscampus „Mobilität der Zukunft“ bereiten KIT und Universität Stuttgart Ideen und Geschäftsmodelle vor Mehr |